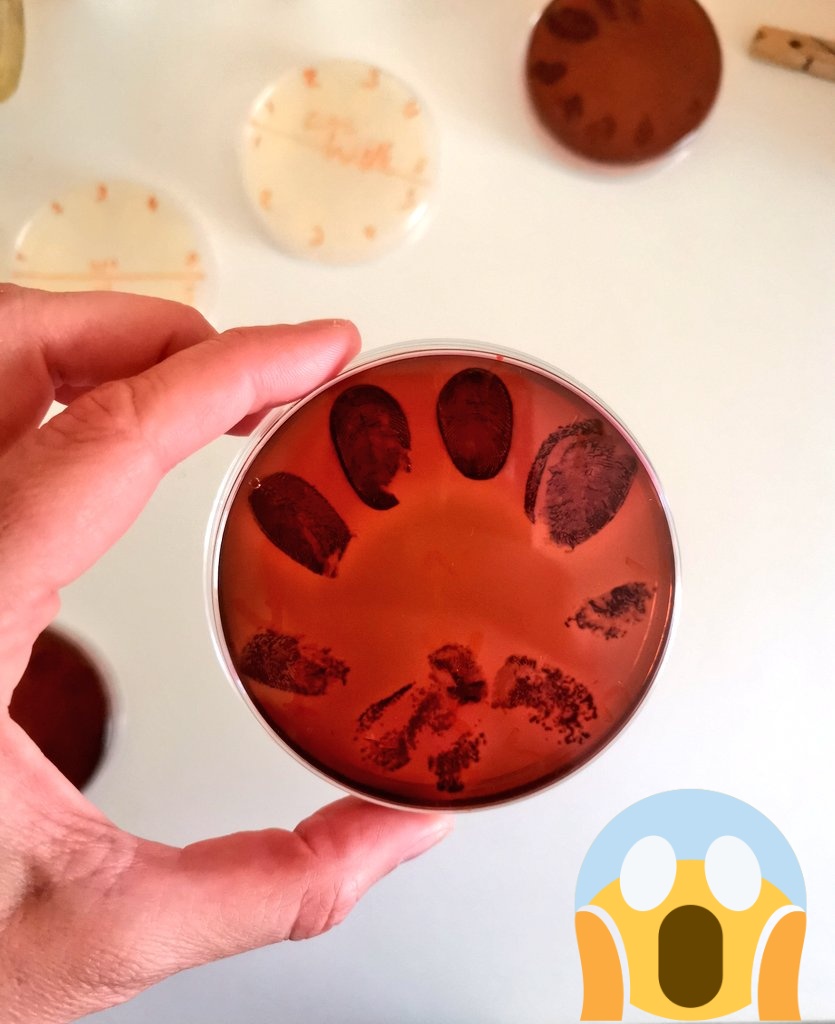
Dr. Rebecca Cavanagh (PhD) tweet media

@Munsterrugby Flanagan should go. Despised by players and caused many good people to leave Munster. CEO should be getting CV ready also.
English
John Sweeney
87 posts

@sweeneyj1
Semmelweis hand hygiene scanner with instant visual feedback and reporting encourages proper hand hygiene . www.handinscan .com




















Out and about today on the neuro wards with @megh_pandit and @AnnySykes7 We were impressed! Here’s Meghana trying out the learning resources. @NurseFlo4 you’ve a great team there!








Zoono, Over 100 lab tests have been carried out WORLDWIDE & proven that Zoono kills 99.99% of bacteria. LONG LASTING protection 30 days on Surfaces 24 Hours on Skin Contact us at info@zoono.ie #hseguidelines #irelandvscovid #covid19 #coronavirus #staysafe #stayhealthy #zoono